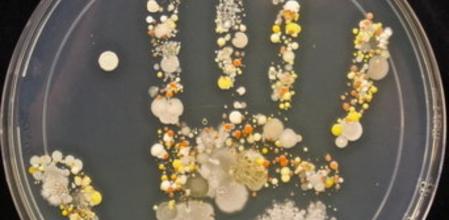
Imagen de la huella bacteriológica de la mano de un niño de ocho años

Barcelona. (Redacción).- Reza el dicho que una imagen vale más que mil palabras. Y eso es lo que pensó Tasha Sturm, profesora del colegio californiano Cabrillo, en EE.UU. Para explicar a sus alumnos la importancia de lavarse las manos al regresar, por ejemplo, de la calle, inmortalizó la huella bacteriológica de la mano de su hijo de ocho años. Y la fotografía no deja lugar a dudas: nuestras manos sin lavar están repletas de bacterias.
La profesora, que ha explicado su peripecia en una entrada en Microbe World (el portal de la Sociedad Estadounidense de Microbiología), muestra la espectacular imagen de la mano de su pequeño que obtuvo a través de la utilización de una placa de Petri.
Sturm utilizó la placa esterilizada y agar tripticasa de soja, un medio de crecimiento bacteriano, y, acto seguido, presionó suavemente los dedos y la palma de su hijo para que hicieran contacto con el agar. Después, cubrió la placa y la introdujo en una incubadora a la temperatura del cuerpo humano (unos 37 grados) durante un día. A continuación, dejó la placa a temperatura ambiente (unos 22 grados) durante unos días más. Y voilà!, las bacterias que colonizaban la mano de su pequeño aparecieron por arte de magia.
Seguramente, sus alumnos, a partir de ahora, visitarán más el lavabo de lo que lo hacían para lavarse las manos más a menudo.